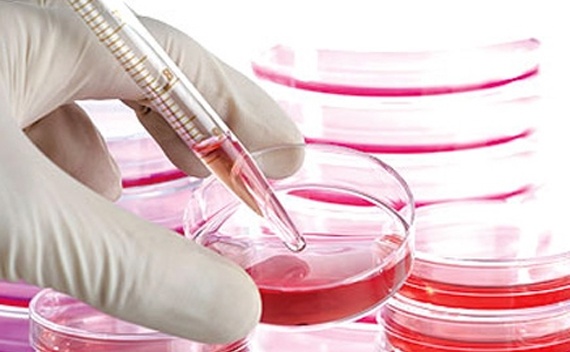
نتائج واعدة لعلاج إصابات النخاع الشوكي بالخلايا الجذعية

نتائج واعدة لعلاج إصابات النخاع الشوكي بالخلايا الجذعية
قالت شركة أسترياس بيوثيرابيتكس إن البيانات الأولية لدراسة صغيرة أظهرت أن علاج الخلايا الجذعية الرائد يمكن أن يحسن الحركة لدى مرضى أصيبوا بالشلل نتيجة إصابة في النخاع الشوكي. وارتفعت سهم الشركة 25% إلى 5.26 دولار خلال تعاملات اليوم. وعقار ايه.اس.تي او.بي.سي-1 هو أول منتج مستخلص من أجنة بشرية يدخل مرحلة التجارب على البشر.
ونجاح العقار ضروري لاثبات أن ابحاث الخلايا الجذعية للأجنة يمكن أن تعالج أمراضا مثل السرطان والشلل الرعاش وحالات صحية خطيرة مثل نقص المناعة والجلطات وإصابات النخاع الشوكي. وأظهرت البيانات أن شدة الإصابة في النخاع الشوكي تراجعت لدى المريض الأول كما تمكن مريضان آخران من استئناف برامج التأهيل فور حقنهما بالخلايا الجذعية. واختبرت دراسة سابقة مزايا جرعة صغيرة من مليوني خلية جذعية أعدت لتتطور داخل الجهاز العصبي.
واشترت أسترياس عقار او.بي.سي-1 عام 2013 من شركة جيرون التي كانت في ذلك الوقت رائدة أبحاث الخلايا الجذعية ثم قررت التركيز على تطوير عقاقير لعلاج السرطان.
واختارت جيرون التخلي عن علاج الخلايا الجذعية عام 2011 بعد أن اصطدم البحث بجدل حول الاجهاض مما دفع عددا من شركات التكنولوجيا الحيوية إلى التزام الصمت بشأن أبحاثها.
وكان ما كشف في الآونة الأخيرة عن بيانات الدراسة الصغيرة التي جاءت بنتائج ايجابية أول ما يعلن عن هذا العلاج منذ أكثر من عامين. وقال كبير المديرين التنفيذيين لرويترز في اوائل أغسطس إن أسترياس تتطلع لاثبات شفاء أربعة مرضى من بين عشرة عولجوا بعقار او.بي.سي-1 مقارنة بمريضين من عشرة حققا نفس التقدم دون أي علاج. وتتوقع أسترياس نشر بيانات السلامة الكاملة من النصف الأول من الدراسة في وقت لاحق من العام.